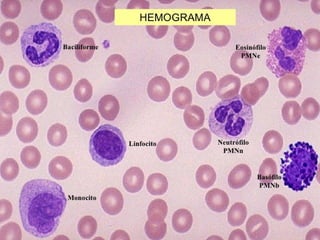
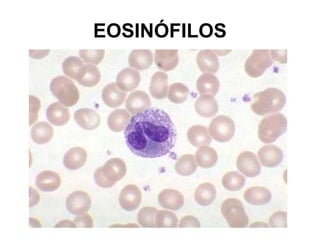
EOSINÓFILOS
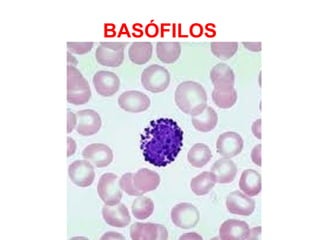
BASÓFILOS
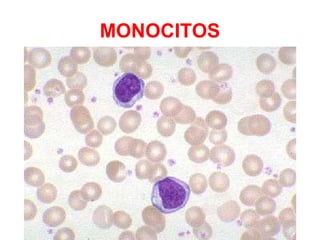
MONOCITOS
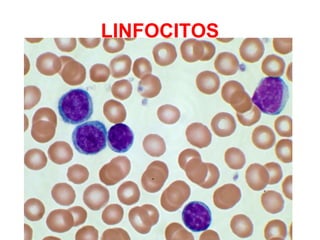
LINFOCITOS

El documento proporciona información sobre conceptos básicos de inmunidad como órganos linfoides, barreras defensivas, inflamación, inmunidad innata y adaptativa, células del sistema inmunitario. Explica el sistema del complemento, citocinas, leucocitos como neutrófilos, eosinófilos, basófilos, monocitos y linfocitos. También describe alteraciones como leucopenia, leucemia y mononucleosis infecciosa.